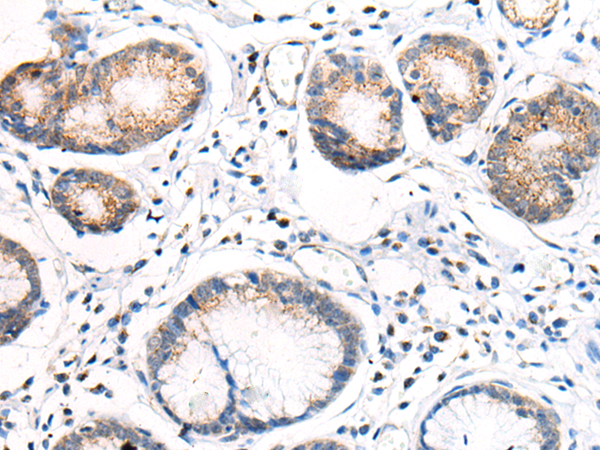

中文名稱: 兔抗ANAPC15多克隆抗體
英文名稱: Anti-ANAPC15 rabbit polyclonal antibody
別 名: APC15; HSPC020; C11orf51
相關(guān)類別: 一抗
儲(chǔ) 存: 冷凍(-20℃)
宿 主: Rabbit
抗 原: ANAPC15
反應(yīng)種屬: Human, Mouse, Rat
標(biāo) 記 物: Unconjugate
克隆類型: rabbit polyclonal
技術(shù)規(guī)格
|
Background: |
ANAPC15 is a component of the anaphase promoting complex/cyclosome (APC/C), a cell cycle-regulated E3 ubiquitin ligase that controls progression through mitosis and the G1 phase of the cell cycle. In the complex, it plays a role in the release of the mitotic checkpoint complex (MCC) from the APC/C: not required for APC/C activity itself, but promotes the turnover of CDC20 and MCC on the APC/C, thereby participating to the responsiveness of the spindle assembly checkpoint. It is also required for degradation of CDC20. |
|
Applications: |
ELISA, IHC |
|
Name of antibody: |
ANAPC15 |
|
Immunogen: |
Synthetic peptide of human ANAPC15 |
|
Full name: |
anaphase promoting complex subunit 15 |
|
Synonyms: |
APC15; HSPC020; C11orf51 |
|
SwissProt: |
P60006 |
|
ELISA Recommended dilution: |
5000-10000 |
|
IHC positive control: |
Human ovarian cancer and human gastric cancer |
|
IHC Recommend dilution: |
40-200 |

購(gòu)物車
購(gòu)物車 幫助
幫助
 021-54845833/15800441009
021-54845833/15800441009
